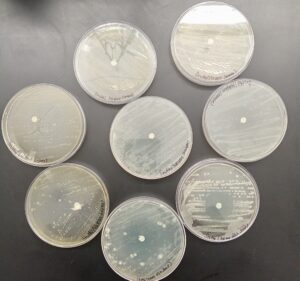
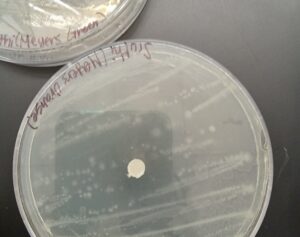

February 26, 2026
Breaking the Bleach Myth: Student’s Independent Science Research Project
When Sruthi Thiyagarajan ’26 began her independent science research project, her inspiration didn’t come from a textbook; it came from home. Growing up in a household where health and wellness were deeply valued, she was surrounded by plant-based and organic products. Her mother, a yoga trainer passionate about natural living, emphasized alternatives to harsh chemicals in everyday life. Botanicals in medicine and cleaning are not a new invention; in earlier times, kitchen gardens provided colonists with an abundance of botanicals – basil, thyme, lavender, and mint – who understood their antiseptic properties to use in the treatment of illnesses in practice if not in theory.
Over time, especially after the COVID-19 pandemic, Thiyagarajan noticed a surge in plant-based cleaning products lining store shelves. They promised to be safer, healthier, and environmentally friendly. But she found herself wondering: were they truly as effective as traditional bleach-based cleaners? Rather than relying on marketing claims or assumptions, she decided to test the science herself.
Her central research question was simple but meaningful: Are plant-based cleaners as effective as bleach-based products in killing bacteria? To answer this, she focused on Escherichia coli (E. coli), a bacterium commonly found in household environments, particularly on dishes and kitchen surfaces. Because certain strains of E. coli can cause illness, it is frequently used in laboratory settings to test disinfectants.
With guidance from her advisor, Dr. Tzanova, Thiyagarajan designed a controlled laboratory experiment using Petri dishes filled with agar, a gel-like substance that supports bacterial growth. She spread E. coli evenly across the agar surface using a sterile inoculating loop, ensuring consistent bacterial coverage. Then, she soaked small paper discs in different cleaning solutions and placed them onto the prepared dishes.
She tested several products: Clorox wipes as her bleach-based comparison, three different varieties of plant-based cleaners containing essential oils such as tea tree, eucalyptus, and lavender, and a standard dish soap containing bleach. To maintain consistency and reliability, she used 20 Petri dishes in total: 10 for plant-based solutions and 10 for bleach-based products. The dishes were placed in an incubator set at 98.6 degrees Fahrenheit, approximating human body temperature. After two to three days, Sruthi examined the results. Around each disc, she looked for what scientists call a “zone of inhibition,” a clear circular area where bacteria failed to grow. The larger this ring, the more effective the cleaning agent.

Measuring the diameter and radius of these clear zones allowed her to quantify the effectiveness of each product. What she discovered surprised her. The plant-based cleaners produced inhibition rings comparable in size to those created by the Clorox wipes. In other words, the plant-derived oils were just as effective at inhibiting bacterial growth as bleach-based cleaners.
This finding challenged a common assumption. Many people believe that natural or plant-based products are gentler but less powerful. However, certain plant oils have well-documented antimicrobial properties. Tea tree oil and eucalyptus oil, for example, contain compounds that can disrupt bacterial cell membranes, preventing growth. Her experiment provided hands-on confirmation that these natural compounds can perform just as effectively in a controlled laboratory setting.
Importantly, Thiyagarajan approached her research with scientific rigor. In her written paper, she not only described her methods and results but also addressed potential sources of error. For instance, she acknowledged that using Clorox wipes instead of a concentrated bleach solution might have influenced the concentration of bleach applied to the discs. Recognizing limitations like this demonstrates an understanding of experimental variables – factors that may affect outcomes and must be considered when drawing conclusions.
Thiyagarajan’s experience has strengthened her interest in biomedical sciences. After taking a biomedical class, she became fascinated by the intersection of medicine, technology, and innovation. She plans to major in biomedical engineering, a field that combines engineering principles with medical science to design technologies such as diagnostic tools, medical devices, and AI-driven healthcare systems. Ultimately, she hopes to become a dermatologist, applying both scientific knowledge and technological advancements to patient care.
Her project reminds us that science often begins with simple questions. Instead of accepting claims at face value, Thiyagarajan gathered data, measured results, and let evidence guide her conclusions. That mindset, curious, analytical, and open to surprise, is what defines a true scientist.